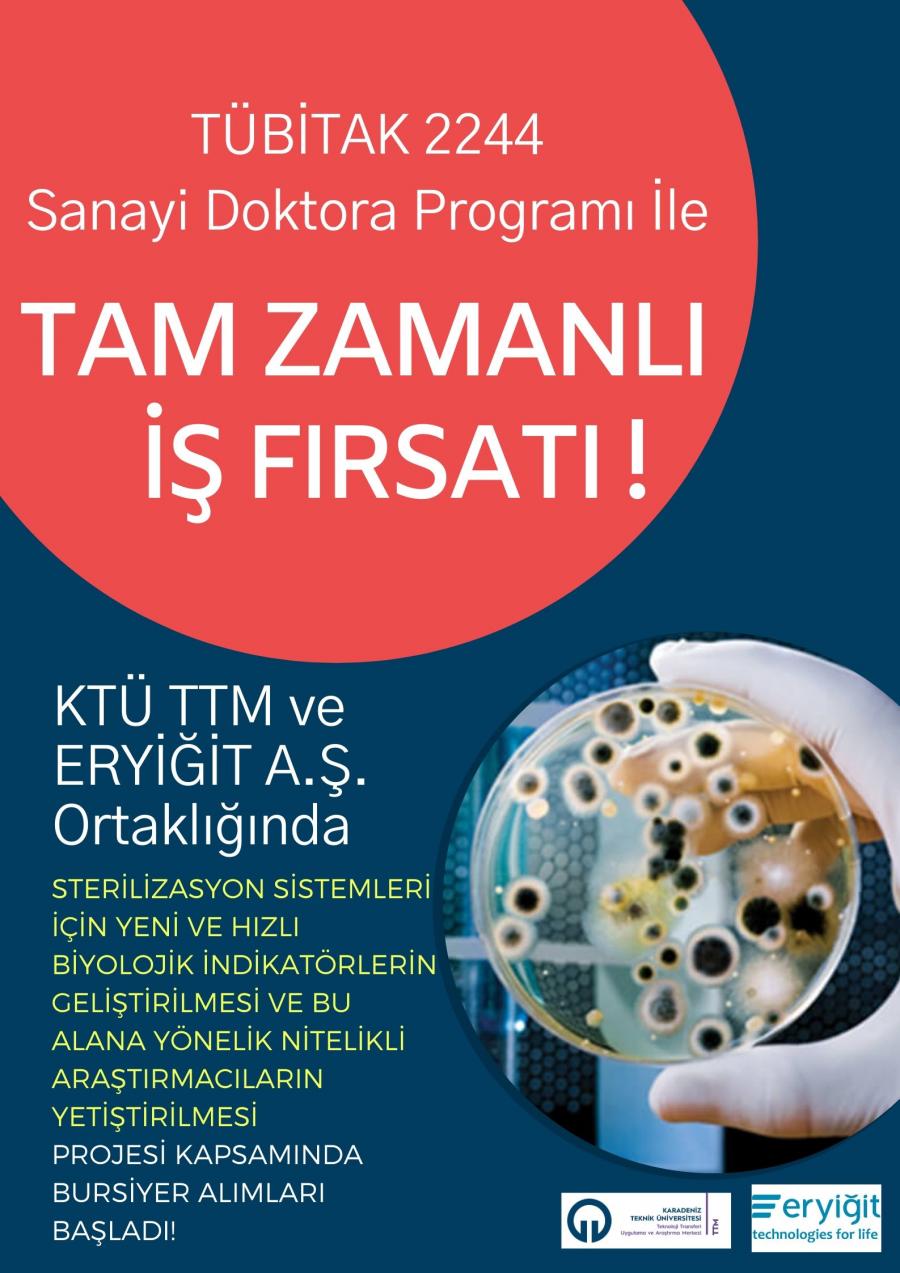

TÜBİTAK 2244 Sanayi Doktora Programı İle Tam Zamanlı İş Fırsatı!
Doktoranızı yaparken sağlık sektöründe Türkiye’nin önde gelen tıbbi cihaz üreticilerinden biri olan ERYİĞİT Endüstriyel Mak. Ve Tıbbi Cih. A.Ş.’de deneyim kazanmak, Ar-Ge Merkezi tecrübesi ve doktora sonrası istihdam fırsatı yakalamak için geç kalmadan başvurun!
TÜBİTAK tarafından sanayide ihtiyaç duyulan doktora derecesine sahip nitelikli insan kaynağının yetiştirilmesi ve sanayide doktoralı araştırmacı istihdamının teşvik edilmesi amacıyla başlatılan 2244 Kodlu Sanayi Doktora Programı çerçevesinde, Karadeniz Teknik Üniversitesi, ERYİĞİT Endüstriyel Mak. Ve Tıbbi Cih. A.Ş ortaklığında Sanayi Doktora programı için bursiyer başvuruları alınmaya başlandı.
Programa dahil olacak adayların doktora programı kapsamında çalışma zamanlarının en az yarısını ilgili firma bünyesinde geçirerek, sanayide uygulamalı olarak deneyim kazanmaları planlanmaktadır.
Başvuru Şartları:
Aşağıda belirtilen alanlarda doktora başvuruları alınacaktır. İlgili alanlarda tez aşamasına geçmemiş doktora öğrencileri de başvuruda bulunabilecektir.
Önemli: Programa başvuruda bulunabilmek için doktoranın Karadeniz Teknik Üniversitesi’nde yapılıyor olması gerekmektedir. Farklı üniversitelerden başvuru ve yatay geçiş işlemleri için Karadeniz Teknik Üniversitesi Fen Bilimleri Enstitüsü ile iletişime geçilmesi gerekmektedir.
|
Ana Bilim Dalı |
Bilimsel ve Teknolojik Faaliyet Alanı |
Sayı |
|
Moleküler Biyoloji ve Genetik Bölümü |
Gen Mühendisliği |
1 |
|
Biyoloji Bölümü |
Moleküler Biyoloji |
2 |
2244 Sanayi Doktora programı çerçevesinde adaylara aşağıdaki imkanlar sağlanacaktır.
Başvuru için e-posta yoluyla iletilmesi gerekli belgeler:
-Lisans ve yüksek lisans mezuniyet notları 4’lük sisteme göre en az 2,40 veya 100’lük sisteme göre en az 62,66 olmalıdır.
-Lisans diplomasıyla doktora programlarına başvuru için lisans mezuniyet notu 4’lük sisteme göre en az 3,2/4 veya 100’lük sisteme göre en az 81,33 olmalıdır.
-Tezli yüksek lisans diplomasıyla doktora programlarına başvuracak adaylar için en az 70 puan
-Lisans diplomasıyla doktora programlarına başvuracak adaylar için en az 80 puan
- YDS’den en az 60 puan almış olmak. YDS belgesi geçerlilik süresi 5yıldır.Kurulca kabul edilen eşdeğer belgeler için ise 2 yıldır. Üniversitelerin yapmış oldukları İngilizce Muafiyet belgeleri 3 yıl geçerlidir. Muafiyet belgesi olmayanlar KTÜ Yabancı Diller Yüksek Okulunun yapacağı muafiyet sınavına girebilir
E-posta: ktutto@ktu.edu.tr
İrtibat Tel: 0462 377 16 98 – 16 94 – 16 92 – 16 91
14 Temmuz 2020